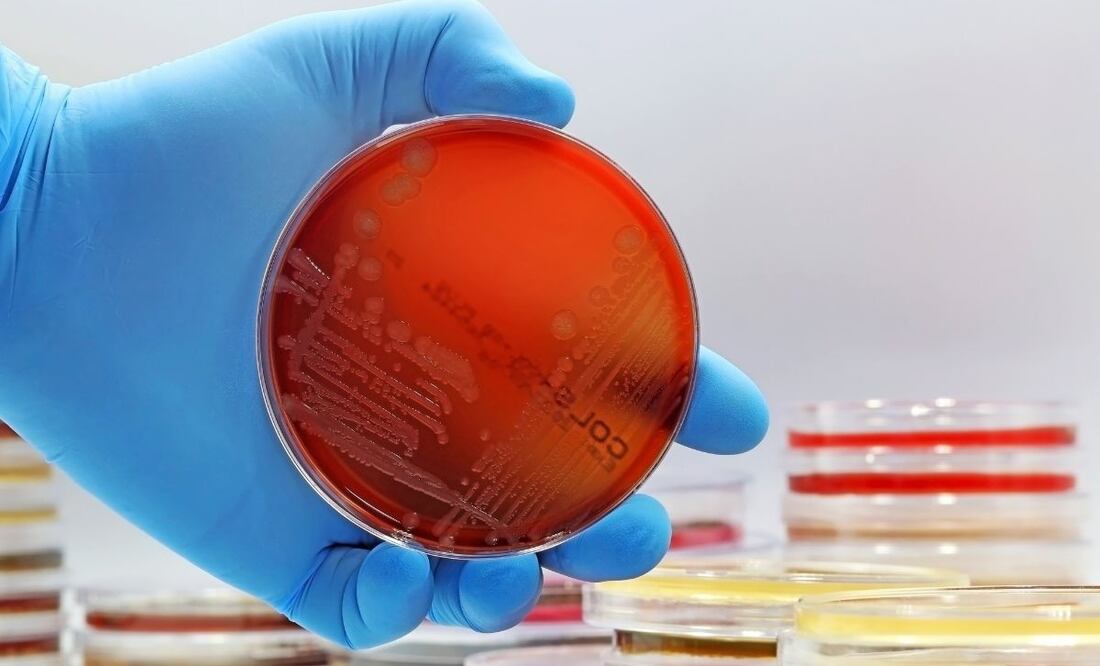
Foto: Getty Images
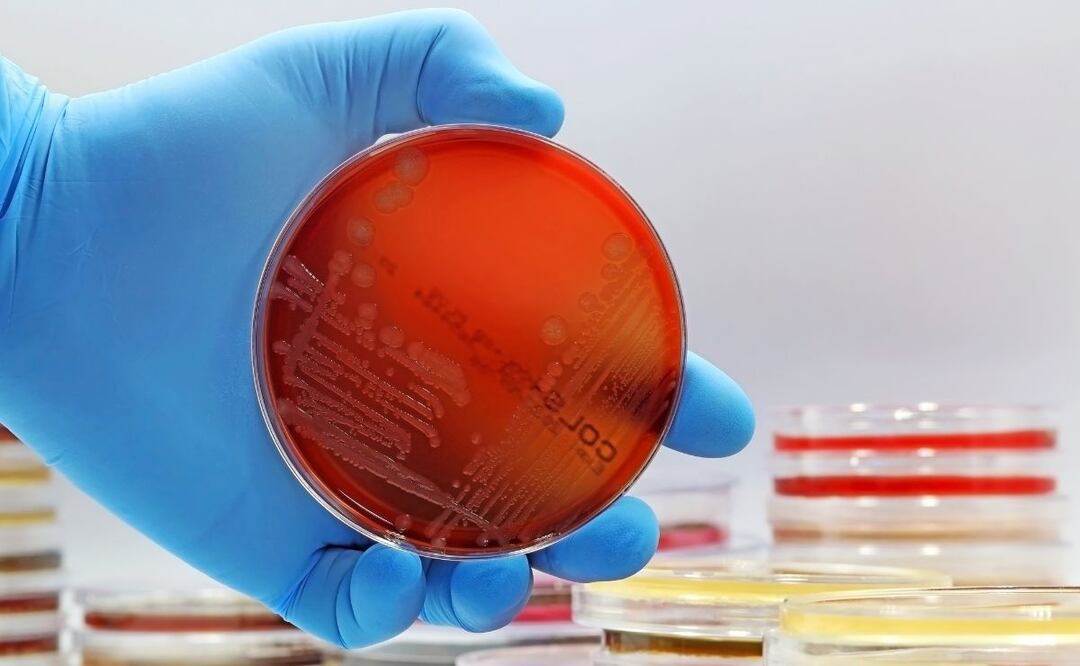
Foto: Getty Images

En el marco del incremento de temperaturas, la Secretaría de Salud de Hidalgo (SSH) emitió un llamado urgente a la población para prevenir la infección por Salmonella, una enfermedad bacteriana que afecta el aparato gastrointestinal y cuya incidencia aumenta durante las épocas de calor debido a la rápida descomposición de los alimentos.
La Salmonella se contrae comúnmente por el consumo de alimentos contaminados como carne de res, pollo, pescado, chorizo, huevo, algunos vegetales, y agua contaminada. También puede transmitirse de persona a persona mediante la vía fecal-oral. Los síntomas característicos de esta infección incluyen náuseas, vómito, diarrea (con o sin sangre), fiebre, dolor abdominal y dolor de cabeza.

Ante el riesgo elevado de brotes familiares y comunitarios, la SSH insta a la ciudadanía a adoptar las siguientes medidas de prevención:
- Higiene Sanitaria:
Enterrar el excremento al defecar al ras del suelo, preferiblemente con cal.
Mantener los baños con drenajes limpios.
Lavarse las manos antes y después de ir al baño.
- Manipulación de Alimentos:
Evitar el consumo de pollo crudo o mal cocido. No comprar pollo con coloración verdosa, textura pegajosa, reseco o con olor desagradable.
No descongelar carnes a temperatura ambiente; hacerlo por cocción o en horno de microondas.
Asegurarse de que la carne esté bien cocida.
No usar los mismos utensilios para alimentos crudos y cocidos.
Lavarse las manos con agua y jabón después de tocar carne cruda.
No lavar el pollo; si se hace, evitar salpicar utensilios y otros alimentos, y proceder a lavarlos y desinfectarlos.
- Conservación de Alimentos:
Almacenar adecuadamente los alimentos, manteniendo el pollo crudo en refrigeración o congelación.
Verificar que el pollo y sus derivados se encuentren a temperaturas adecuadas de refrigeración al momento de la compra.
Es crucial involucrar a todo el núcleo familiar en la adopción de estas prácticas para fortalecer el autocuidado de la salud. La SSH subraya la importancia de estas medidas preventivas para evitar infecciones por Salmonella, especialmente durante el verano, cuando las condiciones son más propicias para la propagación de esta bacteria.
Para más información o ante la presencia de síntomas, la población puede acudir a la unidad de salud más cercana. Mantenerse informado y actuar preventivamente es vital para garantizar el bienestar de todos.
[Publicidad]